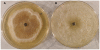

Light converts endosymbiotic fungus to pathogen, influencing seedling survival and niche-space filling of a common tropical tree, Iriartea deltoidea
- PMID: 21305008
- PMCID: PMC3031546
- DOI: 10.1371/journal.pone.0016386
Light converts endosymbiotic fungus to pathogen, influencing seedling survival and niche-space filling of a common tropical tree, Iriartea deltoidea
Abstract
Pathogens are hypothesized to play an important role in the maintenance of tropical forest plant species richness. Notably, species richness may be promoted by incomplete filling of niche space due interactions of host populations with their pathogens. A potentially important group of pathogens are endophytic fungi, which asymptomatically colonize plants and are diverse and abundant in tropical ecosystems. Endophytes may alter competitive abilities of host individuals and improve host fitness under stress, but may also become pathogenic. Little is known of the impacts of endophytes on niche-space filling of their hosts.Here we evaluate how a widespread fungal endophyte infecting a common tropical palm influences its recruitment and survival in natural ecosystems, and whether this impact is modulated by the abiotic environment, potentially constraining host niche-space filling. Iriartea deltoidea dominates many wet lowland Neotropical forests. Diplodia mutila is a common asymptomatic endophyte in mature plants; however, it causes disease in some seedlings. We investigated the effects of light availability on D. mutila disease expression.We found I. deltoidea seedlings to preferentially occur under shady conditions. Correspondingly, we also found that high light triggers endophyte pathogenicity, while low light favors endosymbiotic development, constraining recruitment of endophyte-infested seedlings to shaded understory by reducing seedling survival in direct light. Pathogenicity of D. mutila under high light is proposed to result from light-induced production of H(2)O(2) by the fungus, triggering hypersensitivity, cell death, and tissue necrosis in the palm. This is the first study to demonstrate that endophytes respond to abiotic factors to influence plant distributions in natural ecosystems; and the first to identify light as a factor influencing where an endophyte is placed on the endosymbiont-pathogen continuum. Our findings show that pathogens can indeed constrain niche-space filling of otherwise successful tropical plant species, providing unoccupied niche space for other species.
Conflict of interest statement
Figures

Similar articles
-
Abiotic niche partitioning and negative density dependence drive tree seedling survival in a tropical forest.Proc Biol Sci. 2017 Dec 20;284(1869):20172210. doi: 10.1098/rspb.2017.2210. Proc Biol Sci. 2017. PMID: 29237862 Free PMC article.
-
Variable effects of endophytic fungus on seedling establishment of fine fescues.Oecologia. 2009 Feb;159(1):49-57. doi: 10.1007/s00442-008-1202-z. Epub 2008 Nov 6. Oecologia. 2009. PMID: 18987894
-
Distance-dependence in two Amazonian palms: effects of spatial and temporal variation in seed predator communities.Oecologia. 2004 Jun;140(1):26-35. doi: 10.1007/s00442-004-1554-y. Epub 2004 Apr 15. Oecologia. 2004. PMID: 15085424
-
Endophytic Fungal Diversity and their Interaction with Plants for Agriculture Sustainability Under Stressful Condition.Recent Pat Food Nutr Agric. 2020;11(2):115-123. doi: 10.2174/2212798410666190612130139. Recent Pat Food Nutr Agric. 2020. PMID: 31195952 Review.
-
Ecological implications of anti-pathogen effects of tropical fungal endophytes and mycorrhizae.Ecology. 2007 Mar;88(3):550-8. doi: 10.1890/05-1606. Ecology. 2007. PMID: 17503581 Review.
Cited by
-
The role of biotic interactions in shaping distributions and realised assemblages of species: implications for species distribution modelling.Biol Rev Camb Philos Soc. 2013 Feb;88(1):15-30. doi: 10.1111/j.1469-185X.2012.00235.x. Epub 2012 Jun 12. Biol Rev Camb Philos Soc. 2013. PMID: 22686347 Free PMC article. Review.
-
Geographical ecology of the palms (Arecaceae): determinants of diversity and distributions across spatial scales.Ann Bot. 2011 Dec;108(8):1391-416. doi: 10.1093/aob/mcr146. Epub 2011 Jun 28. Ann Bot. 2011. PMID: 21712297 Free PMC article. Review.
-
Global transcriptional analysis suggests Lasiodiplodia theobromae pathogenicity factors involved in modulation of grapevine defensive response.BMC Genomics. 2016 Aug 11;17(1):615. doi: 10.1186/s12864-016-2952-3. BMC Genomics. 2016. PMID: 27514986 Free PMC article.
-
Intracellular Burkholderia Symbionts induce extracellular secondary infections; driving diverse host outcomes that vary by genotype and environment.ISME J. 2019 Aug;13(8):2068-2081. doi: 10.1038/s41396-019-0419-7. Epub 2019 Apr 24. ISME J. 2019. PMID: 31019270 Free PMC article.
-
Modelling of past, current and future distribution of suitable habitat for Menelik's bushbuck (Tragelaphus sylvaticus meneliki Neumann, 1902) in the Ethiopian highlands.BMC Ecol Evol. 2025 May 12;25(1):47. doi: 10.1186/s12862-025-02367-x. BMC Ecol Evol. 2025. PMID: 40350432 Free PMC article.
References
-
- Janzen D. Herbivores and the number of tree species in tropical forests. American Naturalist. 1970;104:501–529.
-
- Connell JH. On the role of natural enemies in preventing competitive exclusion in some marine animals and in rain forest trees. In: Boer PJD, Gradwell GR, editors. Dynamics of numbers in populations. Wageningen, Netherlands: Centre for Agricultural Publication and Documentation; 1971. pp. 298–312.
-
- Peters HA. Neighbour-regulated mortality: the influence of positive and negative density dependence on tree populations in species-rich tropical forests. Ecology Letters, 2003;6:757–765.
-
- Bell T, Freckleton RP, Lewis OT. Plant pathogens drive density-dependent seedling mortality in a tropical tree. Ecology Letters. 2006;9:569–574. - PubMed
Publication types
MeSH terms
LinkOut - more resources
Full Text Sources
Medical